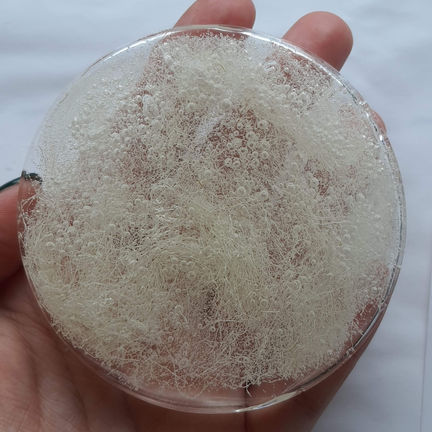

top of page

ELAIN HAF DESIGNS
Product Design Student at Bangor University.
About
ABOUT
Welcome to my Online Portfolio! I'm a Product Design Student passionate about Sustainability and Circular Design. On my last year at Bangor University, I hope to develop the social and environmental challenges the farming community are currently facing. To learn a bit more about me, head over to the ABOUT section in the menu.
Portfolio
ALL PROJECTS
Have a look through the PROJECTS section to see all projects over the last two years. Some projects are parts of a module and some are small projects that kept me busy over the summer. To view my last year project, check out my 3RD YEAR page where I showcase my work through presentations and galleries.
CONTACT

bottom of page